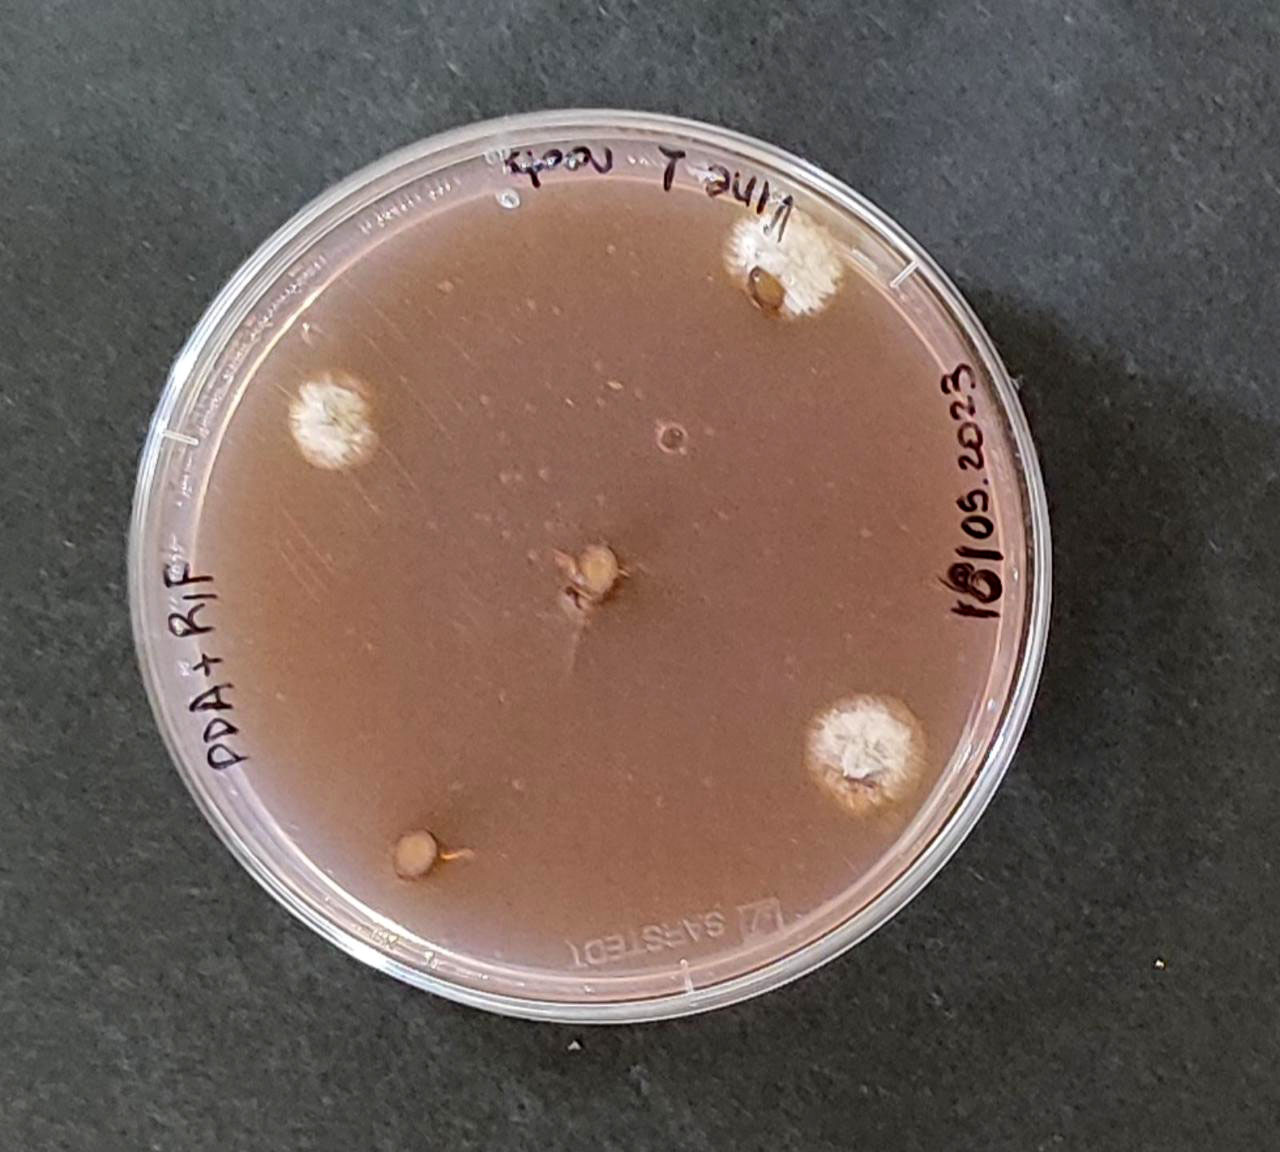

IMPROVITO - Ε.Ε.2
Διαχείριση ασθενειών του ξύλου της αμπέλου με εφαρμογή φυσικών μεθόδων αντιμετώπισης
Στην Ε.Ε. 2 αξιολογήθηκε η αποτελεσματικότητα της εφαρμογής 2 φυσικών μεθόδων αντιμετώπισης ασθενειών των φυτών, της θερμοθεραπείας και του οζονισμένου νερού, με εφαρμογές σε υποκείμενα και κληματίδες σε διάφορες φάσεις της παραγωγικής διαδικασίας στο φυτώριο. Η αξιολόγηση της αποτελεσματικότητας των εφαρμογών έγινε με αξιοποίηση της qPCR. Με την εφαρμογή Θερμοθεραπείας και οζονισμένου νερού μπόρεσαμε στα φυτώρια να μειώσουμε την επιβίωση των παθογόνων ΙΝΑ. Η μείωση της ανίχνευσης ή της ποσοτικοποίησης των παθογόνων ΙΝΑ στα μοσχεύματα κληματίδων/υποκειμένων θα:
1. αυξήσει σημαντικά τα ποσοστά επιτυχίας στην ερριζων εμβολιασμένων φυτών στο φυτώριο, σήμερα είναι στο 55 με 60%, αναμένεται μια αύξηση από 5 έως 7%.
2. Θα αυξήσει την ευρωστία των φυτών κατά την διάρκεια καλλιέργειας στο φυτώριο, συνεπώς θα μειωθούν οι ποσότητες σε λιπάσματα που χρησιμοποιούνται για την καλλιέργεια των φυτών.
3. Θα μειωθεί δραστικά η χρήση φυτοφαρμάκων που χρησιμοποιούνται ήδη στο φυτώριο για την απολύμανση της πρώτης ύλης (μοσχεύματα κληματίδων/υποκείμενα).